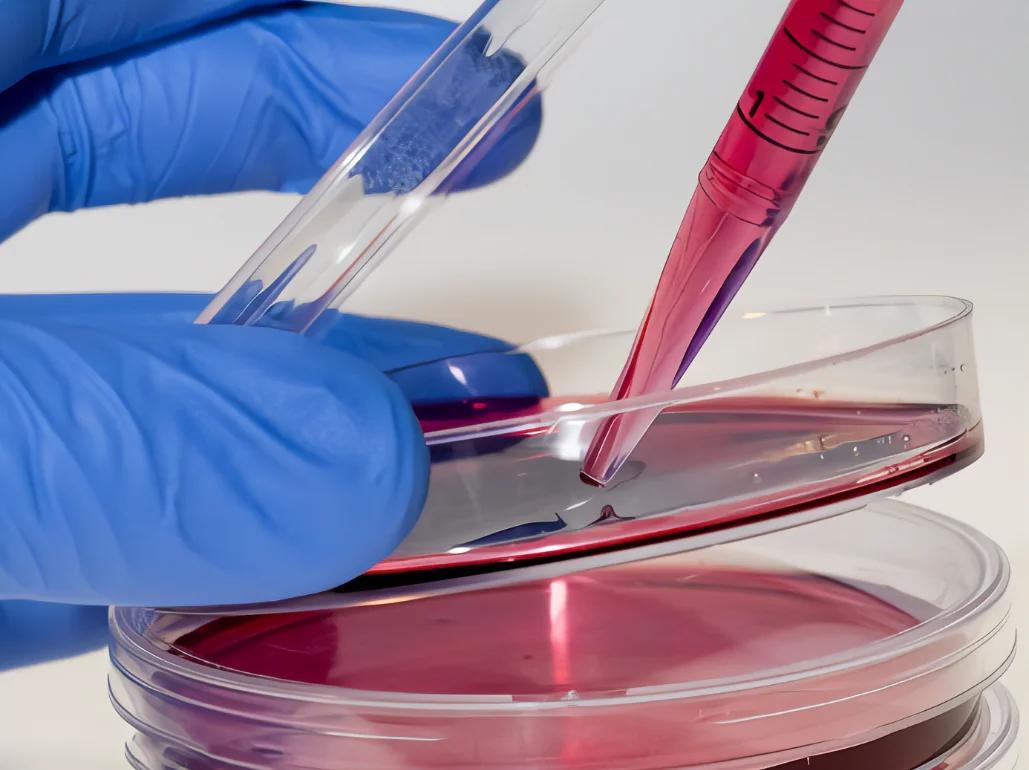

细胞培养肉商业化有哪些关键因素
说起细胞培养肉,商业化是决定企业能走多远的关键哦!咱们拿澳新刚批准的细胞培养鹌鹑肉举例,Vow公司在这方面做得特别牛逼。他们成功的秘诀主要有几个:
-
高端市场定位:Vow直接瞄准高端味蕾,打造了截然不同的产品体验,这样一来利润一开始就很可观,赚得盆满钵满。
-
产能优势:他们现在已经有一座大型“人造肉工厂”,每年能产出30吨蛋白质。更厉害的是,他们正在建一个新工厂,产能是现有的100倍,妥妥的规模化发展!
这些优势让Vow在这个竞赛中跑得很快很远,真是让人眼前一亮。

豫北北坡村的人造肉故事和未来肉类发展有哪些启示
你知道吗?七八十年代的豫北可不是现在这么丰富,物资特别匮乏,肉基本就是“奢侈品”,平时想吃都难。那时人们生活不容易,但脑洞特大:
-
1942年河南大灾,饥荒惨重,有人居然研发出“特效救荒丸”,号称吃上一粒能撑一天,虽然听起来有点搞笑,但也体现了那会儿的求生智慧。
-
到了六七十年代,劳动人民继续“开挂”,没人能吃肉,但他们通过创造“人造肉”的方式,满足了有限的肉类需求,这背后凑足了无数人的智慧和努力。
-
现在回头看,这些故事正好映射了当下细胞培养肉的发展——从无到有,再到大规模商业应用,技术和市场都在飞速进步。
再加上华为发布的《智能世界2030》报告告诉我们,未来农业和食品不仅要智能化,还能实现个性化定制,每个人都能根据自己的口味甚至健康需求用3D打印获得专属的人造肉,听起来是不是很酷?
相关问题解答
- 细胞培养肉为什么这么受关注?
哎呀,这事儿超有趣!细胞培养肉不光能解决大规模的肉类需求,而且还能极大减少环境压力,想想减少养猪养牛带来的污染,这不就是环保的好帮手嘛!而且,它还能让我们吃上更安全、更干净的肉,真是让人忍不住想试试呢!
- 人造肉和传统肉有什么区别?
人造肉啊,哇塞,最大的不同就是它不是从小动物身上直接来的,而是用细胞培养的方式生长出来的。口感和味道现在越来越接近真肉,甚至还能定制营养成分,感觉挺未来感的。传统肉是老方法,人造肉能帮我们解决很多资源和环保的难题~
- 北坡村的“特效救荒丸”到底是个啥玩意儿?
哈哈,那玩意儿说白了就是穷得没办法大家自创的补饥产品,虽然听着很神奇,但咱们现在知道那种“救荒丸”肯定没什么真正科学依据,更多是那个年代的吃饭“神器”。挺让人震惊农民的创造力的!
- 智能农业和人造肉的发展会对我们日常生活有什么影响?
哎呦,影响可大啦!以后你不仅能吃到口感绝佳、人性化设计的肉类,还能通过智能农业吃到更安全、更绿色的农产品。科技和农业一拍即合,未来的饭桌可能会让你惊呼“哇,科技真能改变生活”!生活品质直线上升,谁不爱呢?
新增评论